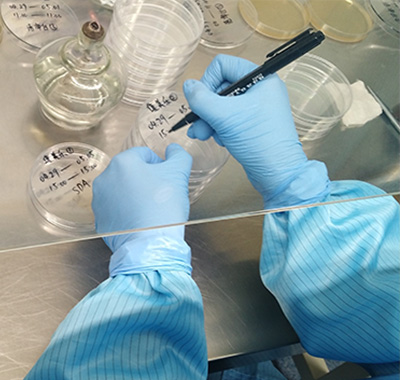

每一个流程都是多次检验的结果

客户咨询

评估报价

签订协议

支付订金

提供资料

分析结果

合格

不合格

检测评估

指导修改
专业解决方案和专业化一体服务

一站式服务

行业经验丰富

专业办理服务
可在全球范围内为客户提供一站式检测认证服务
为多个行业产品提供检测认证服务
深圳市博研检测技术服务有限公司位于深圳市宝安区,是一家主要从事电子及电器产品安全(Safety)、电磁兼容(EMC)、有害物质及成品的分析测试和认证(RoHS)及无线电通讯认证测试和代理的专业服务机构, BEL目前拥有相当规模的Safety、EMC、R&TTE、ROHS等检测的第三方检测实验室,可以从事CE,FCC,ROHS,CCC,UL,TUV,PSE,CB,REACH,EN71,ASTM963,AAA信用体系,ISO认证体系,电池UN38.3,京东、亚马逊等电商质检报告,等各种认证。

为多个行业产品提供检测认证服务